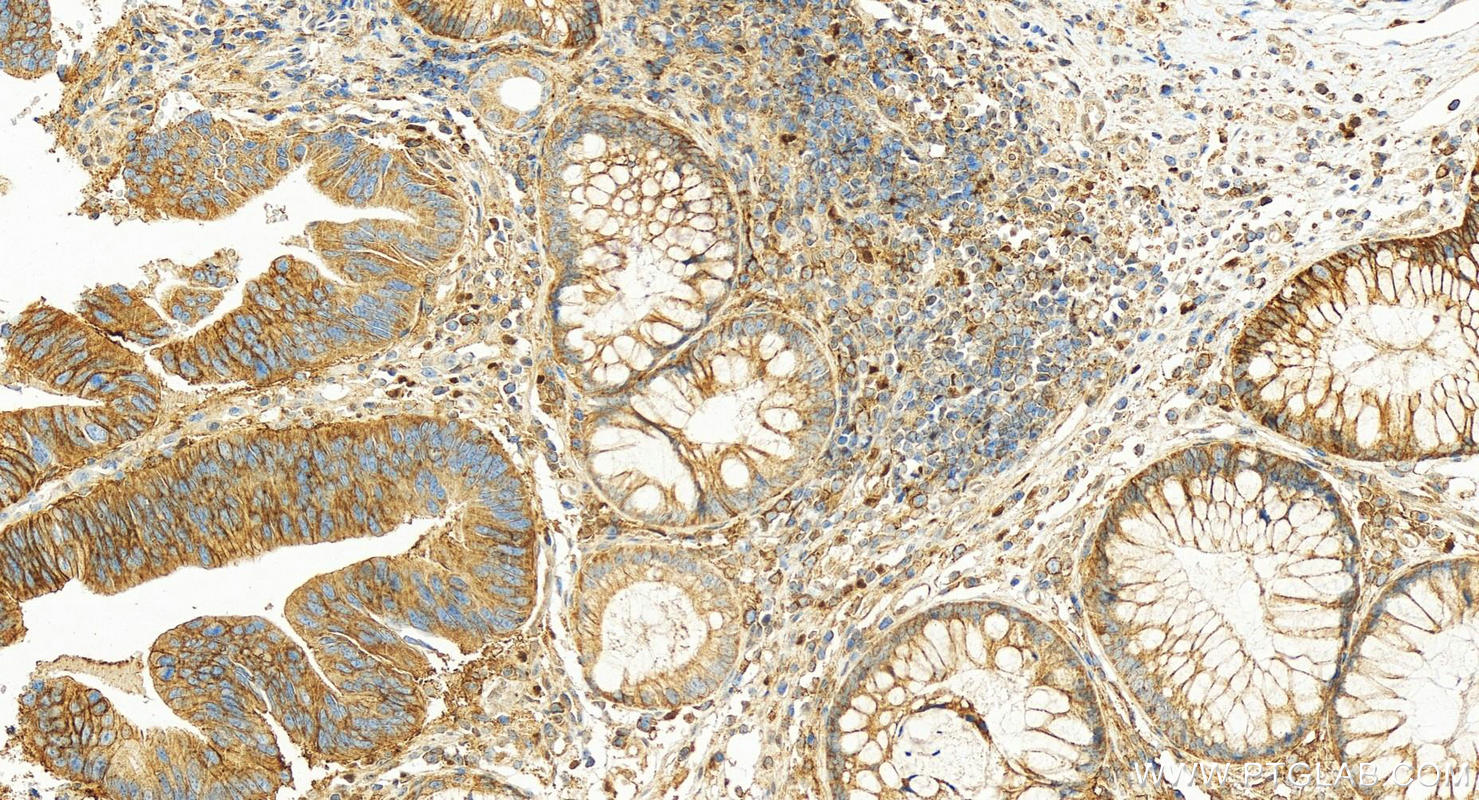
Immunohistochemistry (IHC) staining of human colon cancer tissue using MCT1 Polyclonal antibody (20139-1-AP)

Tested Applications
| Positive WB detected in | BxPC-3 cells, HEK-293 cells, HeLa cells |
| Positive IP detected in | Raji cells |
| Positive IHC detected in | human colon cancer tissue, human breast cancer tissue, human cervical cancer tissue Note: suggested antigen retrieval with TE buffer pH 9.0; (*) Alternatively, antigen retrieval may be performed with citrate buffer pH 6.0 |
| Positive IF/ICC detected in | HeLa cells |
Recommended dilution
| Application | Dilution |
|---|---|
| Western Blot (WB) | WB : 1:2000-1:10000 |
| Immunoprecipitation (IP) | IP : 0.5-4.0 ug for 1.0-3.0 mg of total protein lysate |
| Immunohistochemistry (IHC) | IHC : 1:800-1:3200 |
| Immunofluorescence (IF)/ICC | IF/ICC : 1:50-1:500 |
| It is recommended that this reagent should be titrated in each testing system to obtain optimal results. | |
| Sample-dependent, Check data in validation data gallery. | |
Published Applications
| KD/KO | See 9 publications below |
| WB | See 72 publications below |
| IHC | See 31 publications below |
| IF | See 28 publications below |
| IP | See 1 publications below |
Product Information
20139-1-AP targets MCT1 in WB, IHC, IF/ICC, IP, ELISA applications and shows reactivity with human samples.
| Tested Reactivity | human |
| Cited Reactivity | human, mouse, rat, bovine |
| Host / Isotype | Rabbit / IgG |
| Class | Polyclonal |
| Type | Antibody |
| Immunogen |
CatNo: Ag14098 Product name: Recombinant human MCT1 protein Source: e coli.-derived, PGEX-4T Tag: GST Domain: 451-500 aa of BC026317 Sequence: EQKANEQKKESKEEETSIDVAGKPNEVTKAAESPDQKDTDGGPKEEESPV Predict reactive species |
| Full Name | solute carrier family 16, member 1 (monocarboxylic acid transporter 1) |
| Calculated Molecular Weight | 500 aa, 54 kDa |
| Observed Molecular Weight | 38-45 kDa |
| GenBank Accession Number | BC026317 |
| Gene Symbol | MCT1 |
| Gene ID (NCBI) | 6566 |
| RRID | AB_2878645 |
| Conjugate | Unconjugated |
| Form | Liquid |
| Purification Method | Antigen affinity purification |
| UNIPROT ID | P53985 |
| Storage Buffer | PBS with 0.02% sodium azide and 50% glycerol, pH 7.3. |
| Storage Conditions | Store at -20°C. Stable for one year after shipment. Aliquoting is unnecessary for -20oC storage. 20ul sizes contain 0.1% BSA. |
Background Information
MCT1, the SLC16A1 gene product, is a trans-membrane symporter involved in lactate and pyruvate transportation. It plays an important role in lactic acid transport and H+ clearance in cancer cells. MCT overexpression had been observed in various cancers and may play an important role in tumorigenesis. Two isoforms of MCT1 exist due to the alternative splicing, with predicted MW of 54 kDa and 46 kDa, respectively. While western blot analysis detected MCT1 at an apparent molecular mass of 40-50 kDa.
Protocols
| Product Specific Protocols | |
|---|---|
| IF protocol for MCT1 antibody 20139-1-AP | Download protocol |
| IHC protocol for MCT1 antibody 20139-1-AP | Download protocol |
| IP protocol for MCT1 antibody 20139-1-AP | Download protocol |
| WB protocol for MCT1 antibody 20139-1-AP | Download protocol |
| Standard Protocols | |
|---|---|
| Click here to view our Standard Protocols |
Publications
| Species | Application | Title |
|---|---|---|
Cell Metab Acetate enables metabolic fitness and cognitive performance during sleep disruption | ||
Cell Metab High dietary fructose promotes hepatocellular carcinoma progression by enhancing O-GlcNAcylation via microbiota-derived acetate | ||
Nat Cancer Targeting the bicarbonate transporter SLC4A4 overcomes immunosuppression and immunotherapy resistance in pancreatic cancer | ||
J Exp Clin Cancer Res Lnc AC016727.1/BACH1/HIF-1 α signal loop promotes the progression of non-small cell lung cancer | ||
Clin Cancer Res A Novel Role for DNA-PK in Metabolism by Regulating Glycolysis in Castration Resistant Prostate Cancer. | ||
Cell Commun Signal Strengthening monocarboxylate transporters by adiponectin receptor agonist ameliorates diabetic peripheral neuropathy |
Reviews
The reviews below have been submitted by verified Proteintech customers who received an incentive for providing their feedback.
FH Shiyu (Verified Customer) (10-02-2025) | positive staining result
|
FH Jiangshan (Verified Customer) (10-02-2025) | Very positive about the product
|
FH Angie (Verified Customer) (08-27-2024) | A549 lysate was subjected to western blot with MCT1 antibody used at 1:10000 dilution and incubated at room temperature for 1.5 hours. Secondary antibody Donkey-anti-rabbit (Alexa Fluor 800) used at 1:20000 dilution incubated at room temperature for 1 hour. One thick band at around 40 kDa. Image is shown in grayscale.
 |
FH Xie (Verified Customer) (07-07-2023) | The expression of MCT4 was seen in my samples.
 |
FH Aderonke (Verified Customer) (05-23-2023) | The expression of MCT4 was seen in three of the five cell lines used without an inhibitor. Also, an inhibtor of MCT4, was used at two different concentrations and the expression was decreased in the cells that expressed the protein.
|
FH Huseyin (Verified Customer) (07-28-2022) | I used the antibody with 1:3000 dilution in TBS-T solution O/N and I received correct size bands in Ishikawa cell line.
|